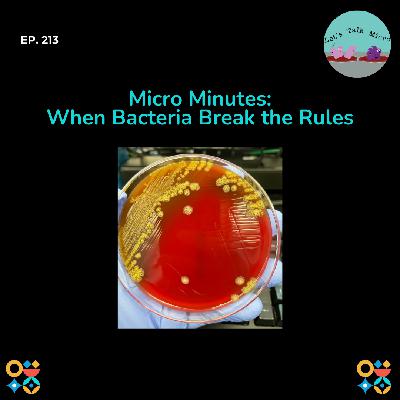
213: Micro Minutes: When Bacteria Break the Rules

Discover
Let's Talk Micro
Let's Talk Micro
Author: Luis Plaza
Subscribed: 138Played: 2,946Subscribe
Share
© Luis Plaza 2021-2025
Description
Clinical microbiology explained in simple terms, suitable for students and microbiologists alike. We discuss organisms, reactions, infectious diseases, and more. Hosted by Luis Plaza, a Medical Laboratory Scientist and microbiologist, who also shares his experiences in the field.
220 Episodes
Reverse
In this Micro Minutes episode, Luis breaks down classic microbiology traits that usually hold true, but not always. From indole-negative E. coli to non-swarming Proteus and oxidase-negative Pseudomonas, this quick episode highlights real-world exceptions that can catch techs and students off guard. Learn how to spot: Indole-negative E. coli (98% rule + inactive biotypes) Lactose-fermenting look-alikes like Citrobacter freundii Proteus species that don't swarm Pseudomonas species that test oxidase negative A fast, practical reminder that no single biochemical test should stand alone. Stay connected with Let's Talk Micro: Website: letstalkmicro.com Questions or feedback? Email me at letstalkmicro@outlook.com Interested in being a guest on Let's Talk Micro? Fill out the form here: https://forms.gle/V2fT3asjfyusmqyi8 Support the podcast: Venmo Buy me a Ko-fi
Welcome to the very first Micro Minutes, a new quick-hit series from Let's Talk Micro designed for students, techs, and anyone who wants fast, practical microbiology insights in under 10 minutes. In this episode, we tackle a common misconception that microbiologists can make at the bench when interpreting a single plate: MacConkey agar. Many assume: "If it doesn't grow on MacConkey, it's not a gram-negative rod." "If it does grow on MacConkey, it must be a gram-negative rod." Both are wrong — and today we break down why. Stay connected with Let's Talk Micro: Website: letstalkmicro.com Questions or feedback? Email me at letstalkmicro@outlook.com Interested in being a guest on Let's Talk Micro? Fill out the form here: https://forms.gle/V2fT3asjfyusmqyi8 Support the podcast: Venmo Buy me a Ko-fi
In the third installment of our special series in partnership with bioMérieux, Luis welcomes back Dr. Sonali Kalathiya, infectious diseases pharmacist and medical advisor at bioMérieux, to explore how innovation is accelerating antimicrobial susceptibility testing (AST). Together they dive into FAST AST—a phenotypic susceptibility test that delivers actionable results directly from positive blood cultures in hours instead of days. They discuss how this technology works, how it complements molecular testing, and how it's transforming patient care, antimicrobial stewardship, and laboratory workflows. From implementation and training to real-world clinical impact, this episode uncovers what it truly means to diagnose resistance at the speed of AST. 🎧 Tune in to learn how faster results are helping clinicians act sooner, optimize therapy, and improve patient outcomes. This episode is sponsored by bioMérieux, a global innovator in infectious disease diagnostics. Resources from this episode: bioMérieux Sepsis Webinar https://info.biomerieux.com/clin_us_2024_ams_handbook?utm_source=podcast&utm_medium=show-notes&utm_campaign=LetsTalkMicro Stay connected with Let's Talk Micro: Website: letstalkmicro.com Questions or feedback? Email me at letstalkmicro@outlook.com Interested in being a guest on Let's Talk Micro? Fill out the form here: https://forms.gle/V2fT3asjfyusmqyi8 Support the podcast: Venmo Buy me a Ko-fi
Just back from IDWeek 2025 in Atlanta, Luis shares the sessions and posters that defined this year's meeting — from next-generation sequencing and diagnostic stewardship to AI in the microbiology lab and new antimicrobials on the horizon. Tune in for insights on: NGS test utilization and stewardship New β-lactamase inhibitors like nacubactam AI's growing role in clinical microbiology Tedizolid and the importance of optimizing existing agents 🎧 Whether you were in Atlanta or following from afar, this episode captures the energy and innovation of IDWeek — and what it means for the future of diagnostics, stewardship, and patient care. Resources Learn more about ID Week : https://idweek.org/ Infectious Diseases Society of America: https://www.idsociety.org/ Stay connected with Let's Talk Micro: Website: letstalkmicro.com Questions or feedback? Email me at letstalkmicro@outlook.com Support the podcast: Venmo Buy me a Ko-fi
En este episodio en español de Let 's Talk Micro, el Dr. Germán Esparza Sánchez , microbiólogo clínico, miembro del CLSI y consultor de la OPS/OMS, comparte las actualizaciones más recientes del documento M100 y cómo impactan la práctica microbiológica. Desde la eliminación de puntos de corte para Burkholderia cepacia hasta los nuevos antibióticos como aztreonam-avibactam, durlobactam-sulbactam y cefiderocol, analizamos los retos de aplicar las guías del CLSI en los laboratorios latinoamericanos, las diferencias epidemiológicas regionales y la importancia de la educación continua para combatir la resistencia antimicrobiana (RAM). Además, el Dr. Esparza comenta sobre el trabajo regional que realizan organizaciones como la Asociación Panamericana de Infectología (API) y COLABIOCLI, que promueven la colaboración científica y la mejora de los laboratorios en América Latina. Enlaces mencionados Asociación Panamericana de Infectología (API) COLABIOCLI Organización Panamericana de la Salud (OPS) Organización Mundial de la Salud (OMS) Conéctate con Let's Talk Micro: Página web: letstalkmicro.com ¿Preguntas o comentarios? 📩 Escríbeme a letstalkmicro@outlook.com Apoya el pódcast: Venmo Buy me a Ko-fi
Puerto Rico is entering a new era in microbiome research. In this episode, Luis speaks with Dr. Filipa Godoy-Vitorino about the newly established Microbiome Center of Puerto Rico — a hub designed to strengthen research, collaboration, and training across the Caribbean. Dr. Godoy-Vitorino shares how the center is helping scientists access expertise in bioinformatics and data analysis, offering bilingual workshops, and expanding representation of Caribbean populations in global microbiome studies. She also discusses the center's vision to connect with international partners, support local innovation, and create opportunities for the next generation of researchers. 🎧 Tune in to learn how this center is putting Puerto Rico on the global microbiome map. Resources and articles mentioned: The Microbiota Vault: microbiotavault.org ISME (International Society for Microbial Ecology): isme-microbes.org ISALA Project (University of Antwerp): isala.be "Solutions to expand microbiome sciences in the Caribbean Region: an insider's perspective" by Filipa Godoy-Vitorino — Trends in Microbiology, 2025. View PDF / Article: ScienceDirect link ScienceDirect Stay connected with Let's Talk Micro: Website: letstalkmicro.com Questions or feedback? Email me at letstalkmicro@outlook.com Support the podcast: Venmo Buy me a Ko-fi
In this second half of our discussion with Dr. Erin McCreary and Dr. Hannah Creager, we dive deeper into how microbiology and antimicrobial stewardship teams collaborate to improve patient outcomes. They unpack how to prioritize breakpoint updates, the pros and cons of cascade reporting, and what nudges can do to guide better prescribing. Then we explore a powerful example of collaboration—the transition from MRSA agar to PCR across hospitals—and what it taught both teams about communication, resource sharing, and patient safety. Finally, Erin and Hannah reflect on lessons learned, first steps for building collaboration, and even share their favorite microbes (spoiler: both picked viruses!). 🎧 Tune in to learn how intentional teamwork between the lab and stewardship can transform patient care and lab efficiency. Stay connected with Let's Talk Micro: Website: letstalkmicro.com Questions or feedback? Email me at letstalkmicro@outlook.com Support the podcast: Venmo Buy me a Ko-fi
Good communication isn't optional—it's essential for patient care. In Part 1 of this two-part series, Dr. Erin McCreary and Dr. Hannah Creager join Luis to talk about how microbiology labs and antimicrobial stewardship teams can collaborate more effectively. They share real-world examples from their system-wide work—aligning AST panels and breakpoints across multiple platforms, navigating reporting challenges like the clindamycin D-test and rifampin comments, and building consistent communication through monthly micro–stewardship meetings. It's a behind-the-scenes look at how strong collaboration turns into better patient outcomes. Stay connected with Let's Talk Micro: Website: letstalkmicro.com Questions or feedback? Email me at letstalkmicro@outlook.com Support the podcast: Venmo Buy me a Ko-fi
The Infectious Diseases Society of America (IDSA) has released new guidelines for the treatment of complicated urinary tract infections. In this episode, we break down the key updates: Changes to the definition of complicated UTIs The role of newer antibiotic agents How and when to use antibiograms A four-step framework for guiding therapy When carbapenems are necessary—and when other options may be just as effective Shorter durations of therapy Join Dr. Barbara Trautner, Dr. Nicolas Cortés-Penfield, and Dr. Kalpana Gupta as they discuss what these guidelines mean for clinicians, microbiologists, and patients. 👉 Stay tuned until the end for a special announcement. Resources from this episode: 2025 cUTI IDSA guidelines Stay connected with Let's Talk Micro: Website: letstalkmicro.com Questions or feedback? Email me at letstalkmicro@outlook.com Support the podcast: Venmo Buy me a Ko-fi
Bloodstream infections can progress rapidly to sepsis—bringing high costs, high mortality, and lasting effects. In the second episode of this series in collaboration with bioMérieux, Luis speaks with Dr. Jeff Cies, Senior Medical Advisor at bioMérieux, about how molecular diagnostics are reshaping bloodstream infection diagnosis. They discuss: Limitations of traditional blood cultures How rapid molecular tests deliver results faster than ever The impact on outcomes, costs, and antimicrobial resistance The role of stewardship programs in maximizing results What the future holds: direct-from-blood testing, nanotechnology, and AI A powerful look at how innovation in microbiology is changing the fight against sepsis and saving lives. This episode is sponsored by bioMérieux, a global innovator in infectious disease diagnostics. Resources from this episode: bioMérieux Sepsis Webinar Stay connected with Let's Talk Micro: Website: letstalkmicro.com Questions or feedback? Email me at letstalkmicro@outlook.com Support the podcast: Venmo Buy me a Ko-fi
Brucella is a familiar name in the lab—but recent updates to the sentinel guidelines are reshaping how we approach this pathogen. In this episode, I'm joined by Dr. Laura Filkins and Dr. Paige Larkin to discuss the latest changes: updates in nomenclature, the removal of certain Brucella species from the select agent list, and the renewed emphasis on safety in the lab. We dive into taxonomy controversies, clinical features of brucellosis, and practical steps laboratorians can take to protect themselves while delivering accurate results. Whether you're a student, laboratorian, or clinician, this conversation highlights what you need to know about the evolving landscape of Brucella diagnostics and safety. Resources from this episode: CDC's Brucellosis Information Page ASM Updates on Brucella Stay connected with Let's Talk Micro: Website: letstalkmicro.com Questions or feedback? Email me at letstalkmicro@outlook.com Support the podcast: Venmo Buy me a Ko-fi
Antimicrobial resistance (AMR) continues to grow as a global health threat, making infections harder to treat and leaving fewer options for patients. The need for new antibiotics is an urgent matter — but traditional discovery methods are slow and limited. In this episode of Let's Talk Micro, Luis is joined by Dr. James Collins, professor at MIT and researcher at the Broad Institute, who is leading efforts to apply AI to antibiotic discovery. We discuss how his team used deep learning to uncover promising new compounds, including NG1 and DN1, which showed activity against drug-resistant Neisseria gonorrhoeae and Staphylococcus aureus. We also talk about the challenges of bringing discoveries from computer models to the clinic, and what this approach could mean for the future of the fight against superbugs. Link to study: https://www.cell.com/cell/abstract/S0092-8674%2825%2900855-4 Check out the website: https://www.letstalkmicro.com/ Questions? Feedback? Send those to letstalkmicro@outlook.com Want to support the podcast? Here's how: Venmo: https://venmo.com/u/letstalkmicro Buy me a Ko-fi: https://ko-fi.com/letstalkmicro
Last week, we discussed early growth isolates for antimicrobial susceptibility testing (AST) and the importance of obtaining results sooner. This week, we revisit an earlier study that looked at early growth but using disk diffusion. In this episode, I was joined by Dr. Carey-Ann Burnham, Dr. Daniel Webber, and Meghan Wallace to discuss their work. Tune in to hear how this approach could help deliver AST results faster, the challenges of adopting early growth methods, and what it means for clinical microbiology labs. This episode was originally released in 2022 (Episode 39: "Talking disk diffusion performed on early growth"). Link to disk diffusion study: https://doi.org/10.1128/jcm.03007-20 Check out the website: https://www.letstalkmicro.com/ Questions? Feedback? Send those to letstalkmicro@outlook.com Want to support the podcast? Here's how: Venmo: https://venmo.com/u/letstalkmicro Buy me a Ko-fi: https://ko-fi.com/letstalkmicro
In this episode of Let's Talk Micro, Dr. Jennifer Dien Bard and Dr. Lucas Osborn discuss their recent study on early growth antimicrobial susceptibility testing (AST). Traditional AST often requires 18–24 hours of incubation of isolates, delaying targeted treatment. Their research shows that using 6-hour early growth isolates with both automated and manual methods delivers accurate results up to 18 hours faster—without added costs or specialized equipment. The conversation explores the study design, agreement rates with standard methods, and what faster AST means for patient care and antimicrobial stewardship. Link to study: https://doi.org/10.1128/jcm.00236-25 Link to disk diffusion study: https://doi.org/10.1128/jcm.03007-20 Check out the website: https://www.letstalkmicro.com/ Questions? Feedback? Send those to letstalkmicro@outlook.com Want to support the podcast? Here's how: Venmo: https://venmo.com/u/letstalkmicro Buy me a Ko-fi: https://ko-fi.com/letstalkmicro
This week, Luis is joined by Dr. Ashlan Kunz-Coyne to discuss some of the newest antibiotics for urinary tract infections (UTIs). They explore why extended-spectrum beta-lactamases (ESBLs) are a growing concern, the impact of E. coli sequence type 131, and where new agents like cefepime–enmetazobactam, sulopenem, and tebipenem fit into treatment. The conversation also highlights clinical data, stewardship considerations, and how the infectious diseases and microbiology communities can work together to preserve these options. Plus, Dr. Kunz-Coyne reveals her favorite bug—Stenotrophomonas maltophilia—and why it's unlike any other. Link to sulopenem episode: https://directory.libsyn.com/episode/index/id/35868135 Check out the website: https://www.letstalkmicro.com/ Questions? Feedback? Send those to letstalkmicro@outlook.com Want to support the podcast? Here's how: Venmo: https://venmo.com/u/letstalkmicro Buy me a Ko-fi: https://ko-fi.com/letstalkmicro
Season 5 premieres today! Antimicrobial susceptibility testing (AST) is essential for guiding effective treatment—but how has it evolved, and what challenges are we still facing? In the first episode of this series in collaboration with bioMérieux, Dr. Andrea Prinzi joins Let's Talk Micro to explore the evolution of AST—from early methods to modern platforms like VITEK 2. We discuss the known issue of outdated breakpoints in clinical practice, the challenges with regulatory hurdles, and the impact of the 21st Century Cures Act. What is the Cures Act, and how does it affect the way breakpoints are adopted? Why are delays still happening? And most importantly—what can laboratories, organizations, and manufacturers do to drive change? Tune in to understand where we've been, where we are, and where we need to go in the world of AST. This episode is sponsored by bioMérieux, a global innovator in infectious disease diagnostics. Resources from bioMérieux: https://info.biomerieux.com/clin_us_2024_ams_handbook?utm_source=podcast&utm_medium=show-notes&utm_campaign=LetsTalkMicro Additional breakpoint links: https://doi.org/10.1128/jcm.00106-25 Check out the website: https://www.letstalkmicro.com/ Questions? Feedback? Send those to letstalkmicro@outlook.com Want to support the podcast? Here's how: Venmo: https://venmo.com/u/letstalkmicro Buy me a Ko-fi: https://ko-fi.com/letstalkmicro
This episode of Let's Talk Micro features Dr. Andrea Prinzi, a clinical microbiologist and frequent contributor to the American Society for Microbiology. Andrea joins the podcast to discuss a critical topic in clinical microbiology: antimicrobial susceptibility testing and breakpoints. Are labs using outdated breakpoints—and what does that mean for patient care? How are breakpoints determined and updated? Dr. Prinzi breaks it all down and shares insights from her article on the subject. Tune in to learn why staying current on breakpoints matters and what steps labs can take to improve antimicrobial stewardship. This episode was originally published on May 5th, 2022. Check out the website: https://www.letstalkmicro.com/ Link to articles: https://asm.org/Articles/2022/February/Updating-Breakpoints-in-Antimicrobial-Susceptibili https://doi.org/10.1128/jcm.00106-25 Questions? Feedback? Send those to letstalkmicro@outlook.com Want to support the podcast? Here's how: Venmo: https://venmo.com/u/letstalkmicro Buy me a Ko-fi: https://ko-fi.com/letstalkmicro
The Clinical Microbiology Procedures Handbook (CMPH) has long been a trusted resource for laboratories. With the release of its 5th edition, this essential reference continues to guide clinical microbiologists through evolving standards, methods, and best practices. In this episode, Luis is joined by the editors‑in‑chief, Dr. Amy Leber and Dr. Carey‑Ann Burnham, to explore what's new in the latest edition, how the CMPH supports day‑to‑day work in the lab, and why it remains a cornerstone in clinical microbiology. (Originally published May 4, 2023.) Check out the website: https://www.letstalkmicro.com/ Questions? Feedback? Send those to letstalkmicro@outlook.com Want to support the podcast? Here's how: Venmo: https://venmo.com/u/letstalkmicro Buy me a Ko-fi: https://ko-fi.com/letstalkmicro
This week, Luis is joined by Dr. Christopher Doern from VCU Health to explore the complex world of diabetic wound cultures. How does diabetes impair wound healing—and what makes these infections so difficult to diagnose and treat? Dr. Doern dives into the microbiology behind diabetic foot wounds, highlighting the impact of bacterial diversity, specimen quality, and the limitations of traditional culture methods. He also shares best practices for workup strategies and antibiotic selection in these often polymicrobial infections. Link to studies mentioned in the episode: https://pubmed.ncbi.nlm.nih.gov/28669650/ https://doi.org/10.1111/j.1742-481X.2011.00937.x https://academic.oup.com/ofid/article/10/10/ofad495/7292955 Want to be added to Dr. Doern's email list? Reach out to christopher.doern@vcuhealth.org Questions? Feedback? Send those to letstalkmicro@outlook.com Want to support the podcast? Here's how: Venmo: https://venmo.com/u/letstalkmicro Buy me a Ko-fi: https://ko-fi.com/letstalkmicro
Recorded live at ASM Microbe 2025, this episode captures the energy of the American Society for Microbiology's annual event. Luis shares his top takeaways from the conference floor—including standout poster presentations, emerging technologies, and trending topics in microbiology. One clear theme dominated this year: rapid diagnostics for identification and susceptibility testing. Tune in for a front-row seat to the latest in clinical microbiology innovation. Questions? Feedback? Send those to letstalkmicro@outlook.com Want to support the podcast? Here's how: Venmo: https://venmo.com/u/letstalkmicro Buy me a Ko-fi: https://ko-fi.com/letstalkmicro

can you post the flow chart here also?